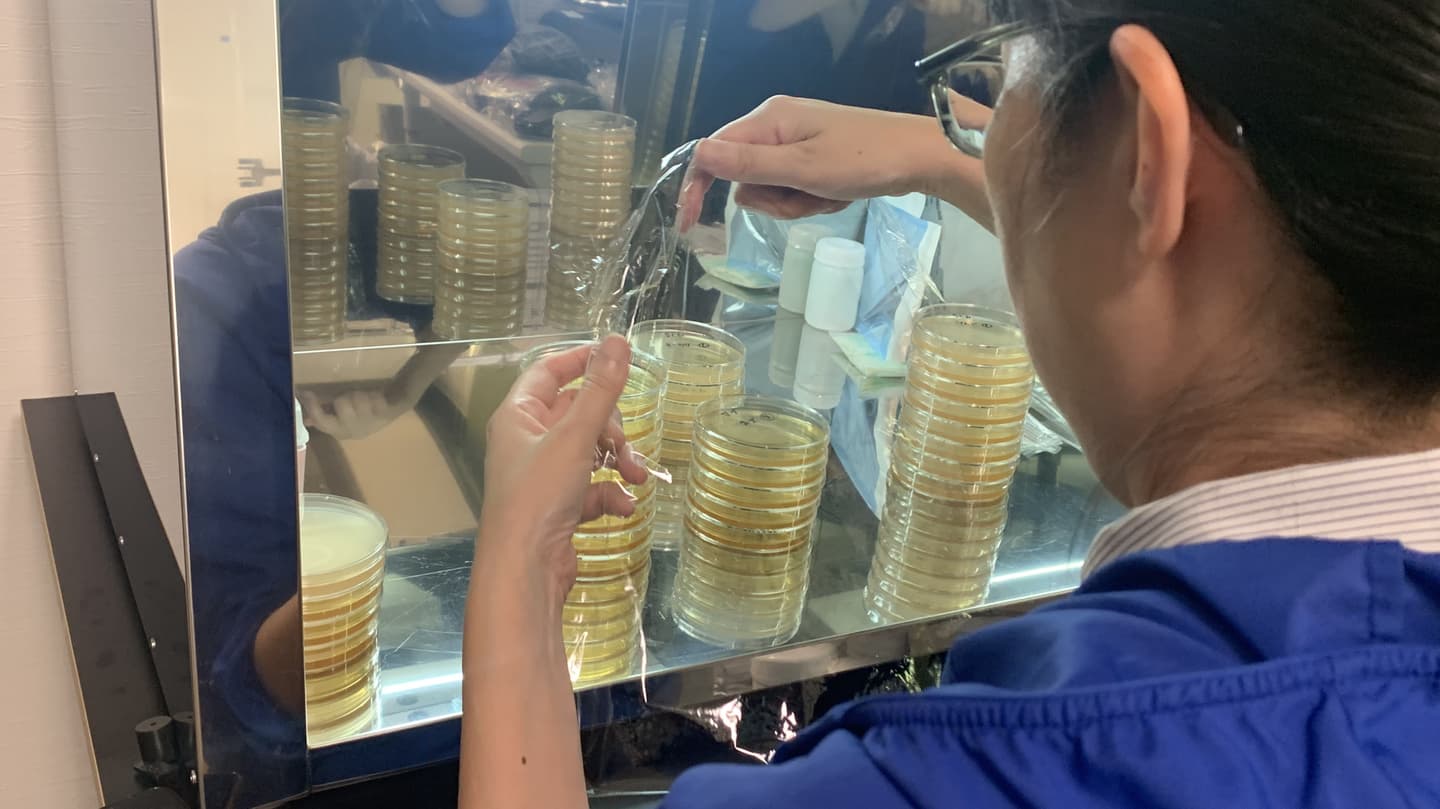

ABOUT NEEDS
株式会社ニーズのご紹介
「お客様のこれからをサポートする」
そのために、新しい「ニーズ」をつくる
今、世の中で求められている「ニーズ」だけではなく、まだ見えない潜在的「ニーズ」を見つけ出し、モノやサービスとして実現し、提供する。
それが株式会社ニーズの考える「ニーズ」であり、「これからをサポートする」ということです。
そして、それを実現するために私たちが重視するのがスピードとフットワーク。
部署の境界を超えたプロジェクトチームも、別組織や新会社をつくるのをいとわないのもそのためです。必要とあれば、業界や業種の壁も超えていきたい。国境も超えていきたい。今、足りない、必要なものがあるなら、必要な場所へ最速で届けたい。大事なのは「これから」の社会のニーズに応えることだと考えます。
私たちは、新しいことに取り組むため、ともに挑戦してくれる新し人を必要としています。
「本当に必要なもの」を、一緒に考え、実現してみませんか?
数字で見るニーズ






QUALITY
私たちの強み

あなたのアイデアが新しいニーズを生み出す
新しい事業に挑戦するために。
時代の変化に迅速に対応するために。
いつでも、誰からでも、新しいアイデアや提案を私たちは求めています。
アイデアが認められれば、部署も職位も横断して、垣根を取り払って全員で実現に取り組みます。
あなたのアイデアを会社全体でバックアップする。
そんなことが、ニーズだからできる。
ぜひ、あなたの力で新しいニーズを作り出してください。
大手にも負けない知識とノウハウでさらなる成長を目指す
時代の変化に柔軟に対応できるよう、小・中ロットを得意とする製造環境、仕入調達環境の構築に力を入れています。
複数のスペックを兼用でき、少しの改造で異なる製品を製造できる生産環境、パートナー企業とのネットワークを活用して、大手企業とも戦える調達環境、ノベルティ企業として多くのアイテムを扱うことで培った知識とノウハウなど、お客様のニーズを速やかに満たす体制を整えています。
それはまた、ユーザー、生活者の声を拾い上げて製品改善の材料とし、それを迅速に提供できることを目指しています。

プライベートブランド・OEMメーカーとして、開発・生産力に磨きをかける
柔軟な提案、細かいスペックや配送条件の要望への対応、できないことがあればできる為の製造設備の増強を前向きに検討する。等など・・・
大手中堅の競合他社が力をいれていない領域への設備投資、生産体制の構築を推進してきました。
これからも競合他社とは一味違う開発・生産力を磨いていきます。
ナショナルブランドメーカーとして、販売チャネルの拡大に取り組む
現在はOEM・プライベートブランドメーカーの側面が強いですが、ナショナルブランドメーカーとしての一つのポジションを確立させることもミッションのひとつとしています。コスメ・ケア用品市場を皮切りとして、ペット市場、薬用化粧品市場へと領域を広げ、商品企画・開発力の強化にも注力しています。
また、メーカーとしてダイレクトに販売するD2C等、新しい販売チャネルの拡大にも取り組んでいます。

NEEDS BRAND
当社オリジナルブランド
月3点に近いペースで、新商品のリリースを行っています。(SKUベース・2022年実績より)
お客様の声に耳を傾け、素早く改善した商品を送り出すために、商品開発でもスピードとフットワークを重視しています。
今後も、様々な使用シーンに特化したボディシートのシリーズや、おしりふき、歯磨きシートなど、人の体に触れる繊細さや精緻さを要求される商品から、さらにはファムテック製品や医薬部外品の開発・製造など新たな領域にも取り組んでいきます。